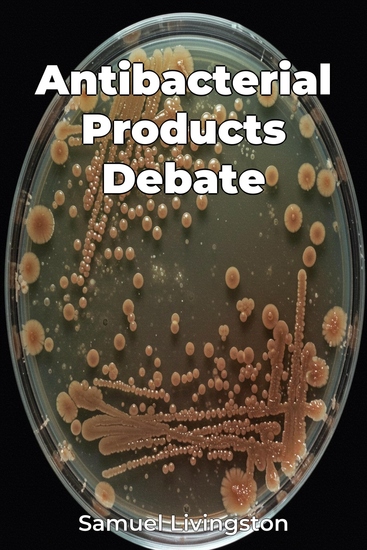

Antibacterial Products Debate
Samuel Livingston
Translator A AI
Publisher: Publifye
Summary
Antibacterial Products Debate explores the pervasive use of antibacterial agents in everyday household products and their broad implications for public health and the environment. It examines whether these products are truly beneficial or if their widespread use poses unforeseen risks. For instance, the book investigates how the overuse of antibacterials can contribute to antibiotic resistance, a growing threat that renders life-saving medications ineffective. It also delves into the impact these products have on our microbiome, the complex community of microorganisms essential for human health, revealing how altering this balance may have unintended consequences. The book progresses by first defining key concepts like "antibacterial" and "antibiotic resistance," before tracing the integration of these products into consumer goods. It then assesses the evidence both supporting and questioning their use, discussing their efficacy in preventing illness and their potential to disrupt beneficial microbial communities. Through accessible language and a balanced approach, the book empowers readers to understand the science behind antibacterial products and make informed decisions about hygiene, offering practical recommendations for a more sustainable approach to infection control.














